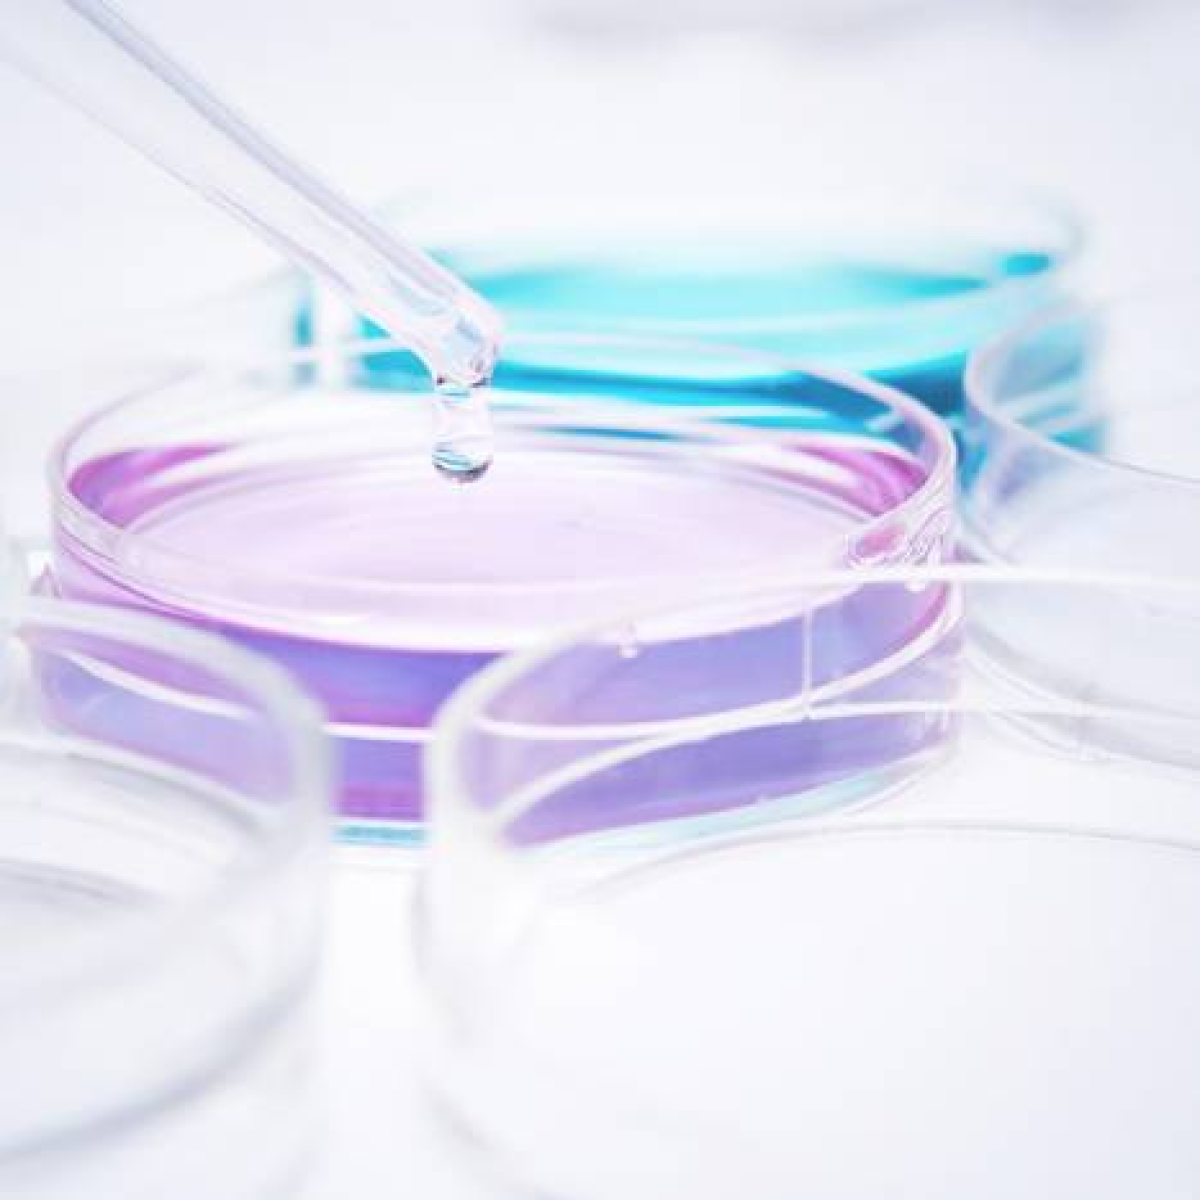

Ammonium
Product description
Jost Chemical manufactures a range of high purity ammonium phosphates, ammonium sulfates, and ammonium citrates. Ammonium phosphates can be used as laboratory reagents or as buffers. Ammonium citrates can be used as buffers, for electronic etching, as analytical reagents, and as a starter material for culture media.
Ammonium Citrate Dibasic
Ammonium Citrate Tribasic
Ammonium Phosphate Dibasic
Ammonium Phosphate Monobasic
Ammonium Sulfate
Read more
Ammonium Citrate Dibasic
Ammonium Citrate Tribasic
Ammonium Phosphate Dibasic
Ammonium Phosphate Monobasic
Ammonium Sulfate
Specifications
| Categories | Additives incl. Flavourings & Colours | AcidulantsAmmonium hydroxide; Vitamins, Minerals | MineralsOther Minerals; Specialised Finished ProductsDietary supplements |
|---|---|
| Sales markets | Western Europe; Eastern Europe; Middle East; Asia; Australia; North America; Africa; Central/South America |
| Supplied from | Poland; United States |
| Certifications | Halal; Kosher; Quality assurance; Sustainable Seafood; Traceable; Vegan; Vegetarian |
Products from other suppliers
❮
❯
-

Sea Cucumber & Oyster Tablet
-

Bifidobacterium longum BORI
-

Pep2Dia®, new bioactive ingredient that regulates blood sugar levels after meals.
-

CRISPYTEC Series
-

GLP-1 Probiotics - Akkermansia muciniphila AH39 & Lactobacillus casei CCFM419
-

BiPRO® 9500 whey protein isolate (WPI)
-

Crispact® Stick packs
-

Nextida® GC
-

Gasbet tablets
-

NEUROMAX®
Ammonium